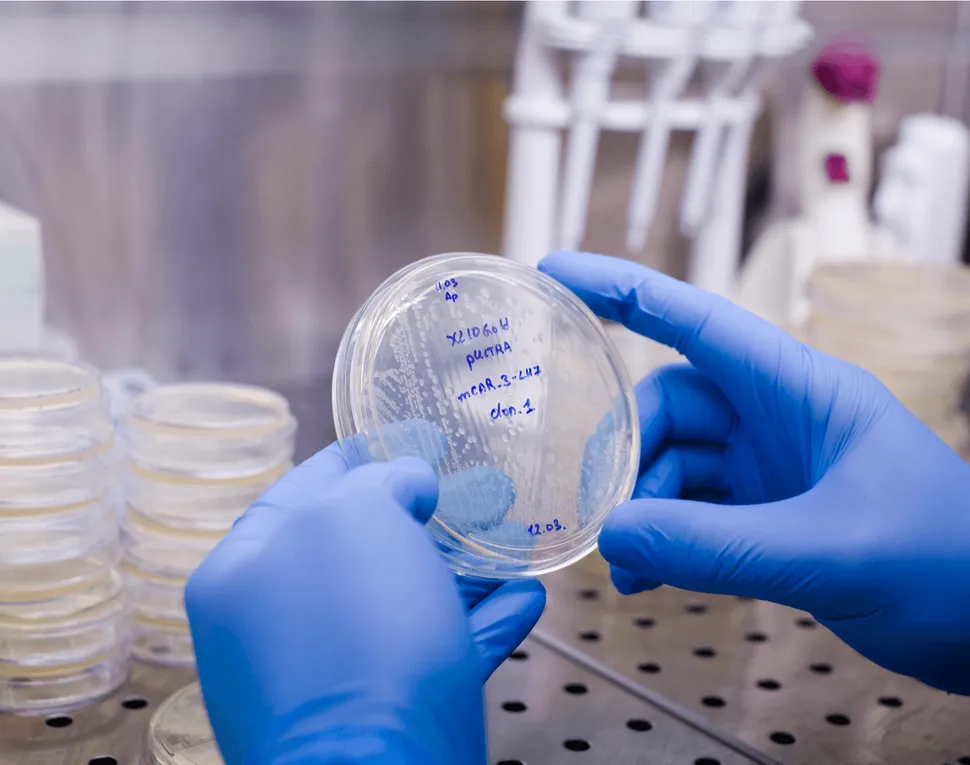
Don't Miss this: Getting to Know the Abecma (ide-cel) CAR T Therapy MC Community Event image

Don't Miss this: Getting to Know the Abecma (ide-cel) CAR T Therapy MC Community Event
The newly FDA-approved treatment, Abecma (ide-cel) CAR T Therapy, has been a popular topic of myeloma-based meetings and articles in recent months. So what will make this upcoming event in the Myeloma Crowd Community any different?
We wanted to take a more basic approach when considering the CAR T therapy. We will explore practical questions surrounding CAR T therapy such as:
- What is the treatment?
- How does it work?
- Who is it for?
- What is the procedure like?
- Who qualifies for it?
- How can you sign up?
- What is recovery like?
And to answer these questions we have multiple myeloma specialist, Dr. Nina Shah from UCSF Health. With experience in the CAR T clinical trials, Dr. Shah has a unique perspective on the treatment and will be able to share her knowledge with us in a clear and precise way.
Don't miss the chance to ask an expert your questions about this new and upcoming therapy. It could be a game-changer in your myeloma journey!
The newly FDA-approved treatment, Abecma (ide-cel) CAR T Therapy, has been a popular topic of myeloma-based meetings and articles in recent months. So what will make this upcoming event in the Myeloma Crowd Community any different?
We wanted to take a more basic approach when considering the CAR T therapy. We will explore practical questions surrounding CAR T therapy such as:
- What is the treatment?
- How does it work?
- Who is it for?
- What is the procedure like?
- Who qualifies for it?
- How can you sign up?
- What is recovery like?
And to answer these questions we have multiple myeloma specialist, Dr. Nina Shah from UCSF Health. With experience in the CAR T clinical trials, Dr. Shah has a unique perspective on the treatment and will be able to share her knowledge with us in a clear and precise way.
Don't miss the chance to ask an expert your questions about this new and upcoming therapy. It could be a game-changer in your myeloma journey!

about the author
Audrey Burton-Bethke
Audrey is a content writer and editor for the HealthTree Foundation. She originally joined the HealthTree Foundation in 2020. Audrey loves spending time with her supportive husband, energetic four-year-old, and new baby.
More on HealthTree Programs
Trending Articles





Get the Latest Multiple Myeloma Updates, Delivered to You.
By subscribing to the HealthTree newsletter, you'll receive the latest research, treatment updates, and expert insights to help you navigate your health.